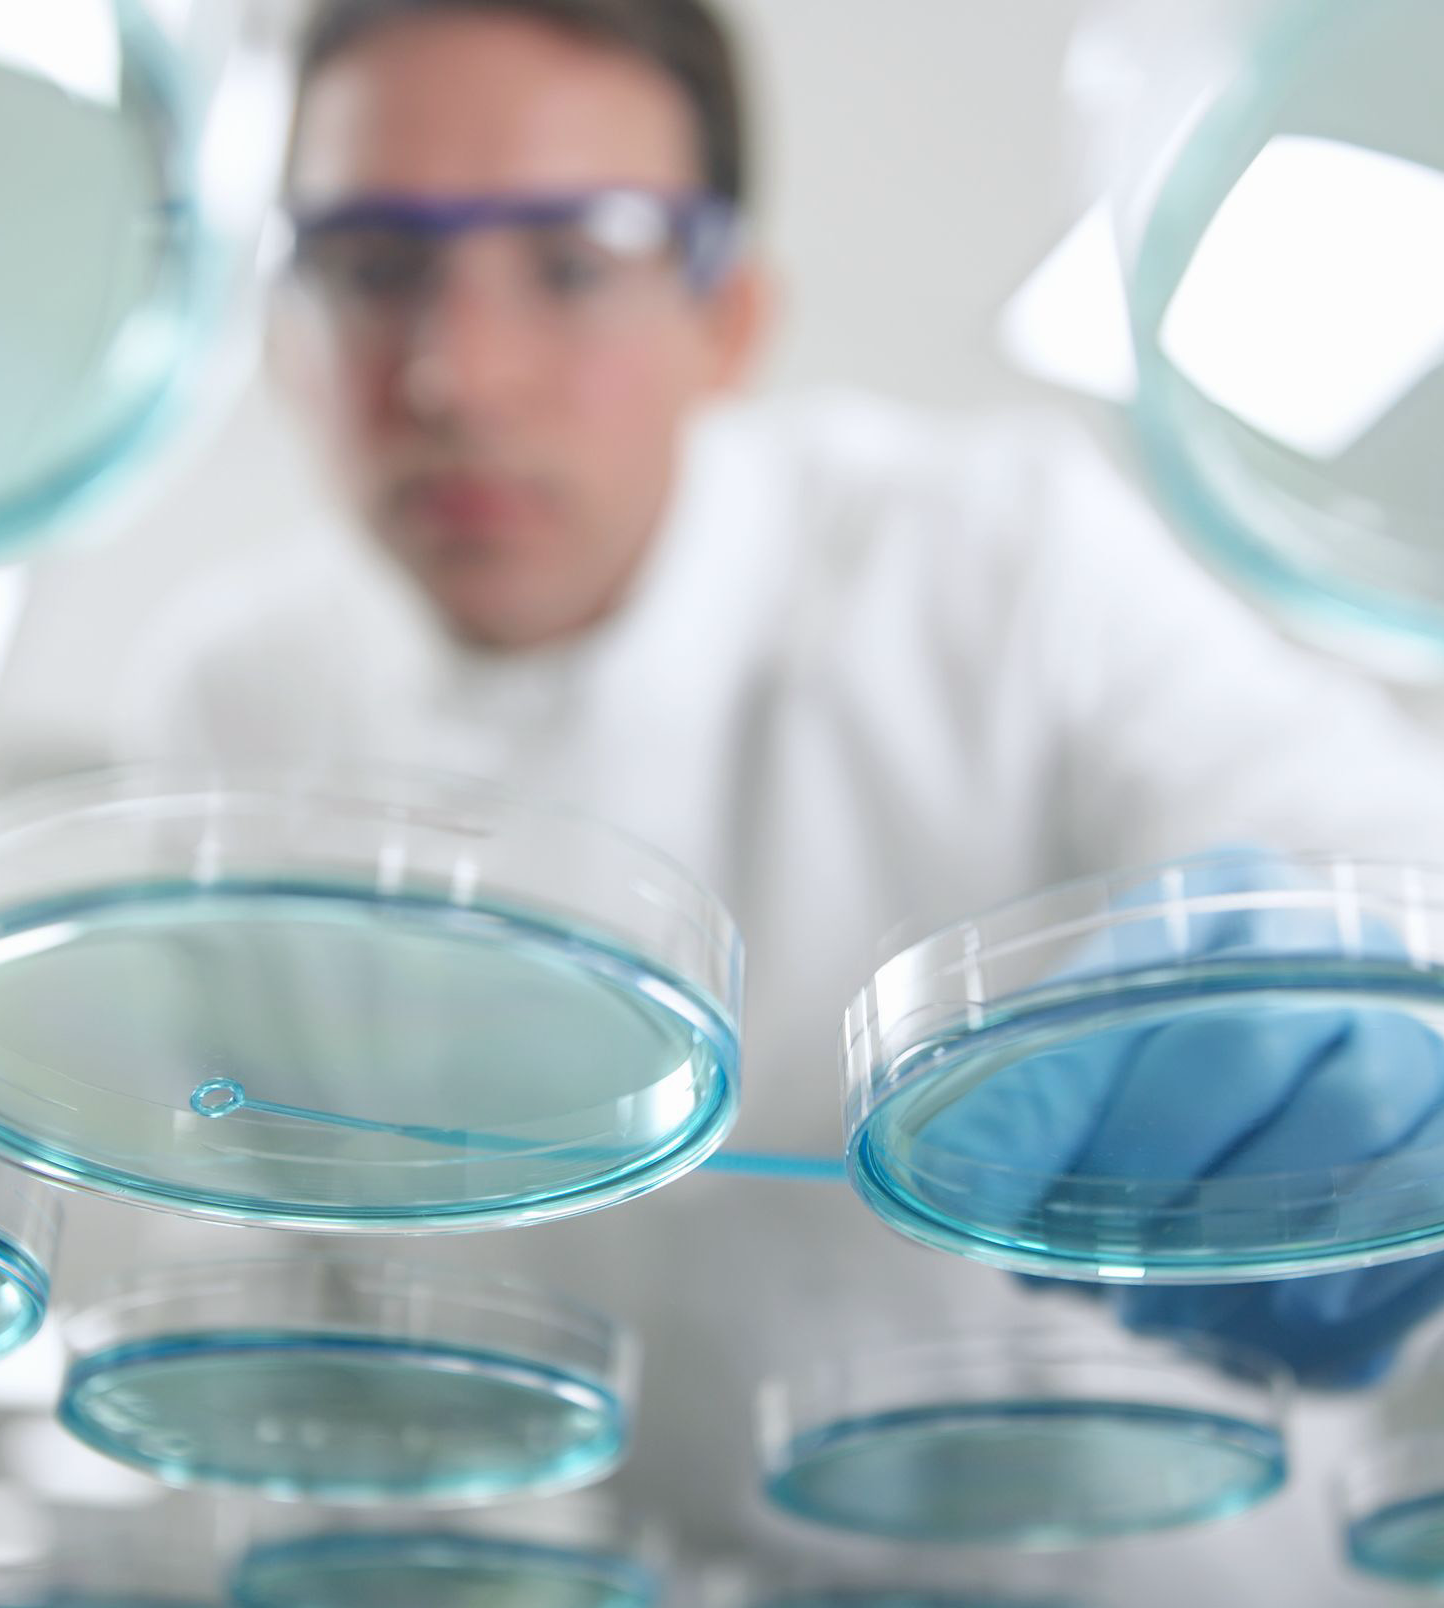
生物药研发实验室信息化解决方案

PK/PD 解决方案 | 群体PK建模助力一种罕见肝病治疗药物的批准

Q&A | 2020年12月XTEDO eCTDmanager 精选Q&A

创腾科技医药顾问团队专业解读2020《药品记录与数据管理规范(征求意见稿)》

生物分析实验室整体解决方案
生物药研发实验室信息化解决方案

化学药研发实验室信息化解决方案

催化剂研发信息化解决方案

GMP实验室QA/QC信息化整体解决方案——实验仪器数据采集管理

GMP实验室QA/QC信息化整体解决方案——实验记录管理